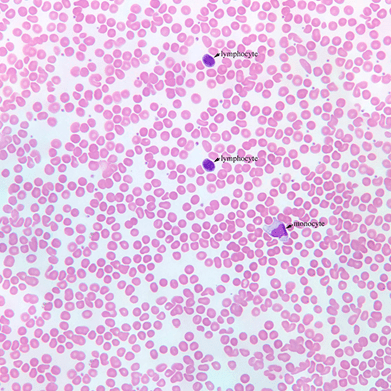
Лейкоцитоз по ГОСТ 25382-82

Микроскопы в ветеринарии и методики по актуальным ГОСТ

Наша компания успешно провела вебинар на тему: "Применение оптических приборов в ветеринарии". Здесь Вы сможете найти основные методики определения заболеваний у животных с использованием микроскопов по современным ГОСТ.
С записью вебинара можете ознакомиться с помощью видео ниже. А также подписывайтесь на наши соцсети, чтобы оставаться в курсе: наш YouTube канал и Instagram!
Бактериологические методики
Бактериологический метод подразумевает под собой выделение и идентификацию культуры возбудителя. С микроскопом это реализуется путём пробоотбора, окрашивания образцов и затем собственно определению вредоносных микроорганизмов. На сегодняшний день процедуру определения можно проводить как оператору лично, так и c помощью специального программного обеспечения, которое поставляют практически все крупные производители микроскопов.
Методика определения бруцеллеза по ГОСТ 33675-2015
С помощью микроскопа определяют бруцеллез бактериологическим методом (выделение и идентификация культуры возбудителя). Для бактериологического исследования на бруцеллез направляют абортированный плод с плодовыми оболочками, от плодов крупных животных направляют селезенку, печень, желудок с содержимым, перевязанный со стороны пищевода и двенадцатиперстной кишки, и околоплодную жидкость.
Сущность бактериоскопического метода заключается в окрашивании мазков и мазков-отпечатков из патологического материала и последующем микроскопическом выявлении клеток бруцелл.

Пробоподготовка: из проб патологического материала делают по два мазка. При исследовании абортированных плодов готовят мазки-отпечатки, а жидкий материал наносят на предметные стекла пастеровской пипеткой. Мазки-отпечатки на одном предметном стекле окрашивают по Козловскому или Стампу, на другом - по Граму, предварительно зафиксировав.
При микроскопии окрашенных мазков, содержащих бруцеллы, должны наблюдаться мелкие, грамотрицательные, расположенные отдельно, попарно или кучно коккобактерии, окрашенные в красный цвет.
Методика определения токсоплазмоза животных по Методическим указаниям
Также бактериологическим методом проводят диагностику на токсоплазмоз по Методическим указаниям по лабораторной диагностике токсоплазмоза животных.
Жидкий материал наносят стерильной пипеткой на предметное стекло, размазывают и сушат на воздухе. Экссудат грудной и брюшной полостей предварительно центрифугируют при 2000 об./мин в течение 15 мин и мазки готовят из осадка. При исследовании плаценты делают разрез котиледона и делают мазки-отпечатки.

Мазки высушивают на воздухе, фиксируют этиловым спиртом в течение 10-15 мин, окрашивают по Романовскому (1-2 капли краски азур-эозина на 1 см дистиллированной воды рН (7,0-7,2) в течение 30-60 мин (зависит от качества краски), промывают дистиллированной водой, высушивают на воздухе и исследуют под иммерсионной системой микроскопа.
Эндозоиты токсоплазмы имеют форму дольки апельсина (полумесяца) с заостренным передним концом. Цитоплазма эндозоитов окрашивается в голубой цвет различной интенсивности, ядро - в красный или красно-фиолетовый.
Для таких задачи отлично подойдёт микроскоп Nikon Eclipse E200 в комплектации с объективами класса Plan Achromat. Бинокулярный сет будет состоять из штатива с встроенным LED осветителем, бинокулярного тубуса, пары широкопольных окуляров, конденсора Аббе и набором объективов Plan Achromat 4х, 10х, 40х, 100х. Если же нужна комплектация с камерой – используется тринокулярный сет. Отличие с предыдущим – в тубусе и наличие камеры.
| Бинокулярный сет MCA76200 Eclipse E200LED MV R Main Body MCB72100 E2-TB Binocular Tube MCK70100 CFI E 10X Eyepiece (FN 20) x2 MCL71100 E2 Abbe Condenser, N.A. 1.25 MRP70040 CFI E Plan Achromat 4X, N.A. 0.10, W.D. 30mm MRP70100 CFI E Plan Achromat 10X, N.A. 0.25, W.D. 7mm MRP70400 CFI E Plan Achromat 40X, N.A. 0.63, W.D. 0.65mm, spring-loaded MRP71900 CFI E Plan Achromat 100X Oil, N.A. 1.25, W.D. 0.23mm, oil-immersion, spring-loaded | Тринокулярный сет MCA76200 Eclipse E200LED MV R Main Body MCB73100 E2-TF Trinocular Tube MCK70100 CFI E 10X Eyepiece (FN 20) x2 MCL71100 E2 Abbe Condenser with objective position guide marking, N.A. 1.25 MCN71100 Blue Filter 33mm MRP70040 CFI E Plan Achromat 4X, N.A. 0.10, W.D. 30mm MRP70100 CFI E Plan Achromat 10X, N.A. 0.25, W.D. 7mm MRP70400 CFI E Plan Achromat 40X, N.A. 0.63, W.D. 0.65mm, spring-loaded MRP71900 CFI E Plan Achromat 100X Oil, N.A. 1.25, W.D. 0.23mm, oil-immersion, spring-loaded |
 |  |
Методика диагностики лептоспироза по ГОСТ 25386-91
Материалом для исследований служит кровь, моча, органы и ткани, а также трупы мелких животных. От трупов крупных животных берут сердце, кусочки паранхиматозных органов, почку, транссудат из грудной и брюшной полостей, перикардиальную жидкость, мочевой пузырь с содержимым, спинномозговую жидкость.
Препараты для микроскопических исследований готовят в виде раздавленной капли. Исследуемый материал наносят пипеткой или бактериологической петлей на предметное стекло и накрывают покровным стеклом, избегая образования пузырьков воздуха. На одном предметном стекле готовят две-три раздавленных капли.

При проведении микроскопических исследований исследуемый материал микроскопируют в темном поле микроскопа при увеличении 40х7-10 или 20x1,5х7, а для более детального рассмотрения препарата - при увеличении 40х10-15 или 40х1,5х10. Типичные лептоспиры представляют собой спиралеподобные тонкие серебристые нити, концы которых, оба или один, загнуты и булавовидно утолщены. При бактериологическом и серологическом методах используется методика темного поля.
| MCA76200 Eclipse E200LED MV R Main Body MCB72100 E2-TB Binocular Tube MCK70100 CFI E 10X Eyepiece (FN 20) x2 MCK70150 CFI E 15X Eyepiece (FN 12) х2 MBL12010 Dark Field Condenser, N.A. 0.80-0.95 MRP70040 CFI E Plan Achromat 4X, N.A. 0.10, W.D. 30mm MRP70100 CFI E Plan Achromat 10X, N.A. 0.25, W.D. 7mm MRP70400 CFI E Plan Achromat 40X, N.A. 0.63, W.D. 0.65mm, spring-loaded MRP71900 CFI E Plan Achromat 100X Oil, N.A. 1.25, W.D. 0.23mm, oil-immersion, spring-loaded | MBA95000 Ci-L Main Body MBB93800 C-TE2 Ergonomic Binocular Tube MAK10110 Eyepiece CFI 10X (FN 22) x2 pcs. MAK99000 CFI UW Eyepiece Guard (for 10X) MBC91110 C-SR2S Right Handle Stage with 2SHolder MBP71316 C-N6ESD Sextuple Nosepiece ESD MBL12010 Dark Field Condenser, N.A. 0.80-0.95, W.D. 4mm MRL00042 CFI Plan Achromat 4X MRL00102 CFI Plan Achromat 10X MRL00202 CFI Plan Achromat 20X MRL00402 CFI Plan Achromat 40X |
 |  |
Как и в случае светлопольной микроскопии будет достаточно использование Nikon Eclipse E200 или Nikon Eclipse Ci-L с набором Plan Achromat объективов, но с добавлением темнопольного конденсора. Также важно помнить, что числовая апертура конденсора должна быть больше апертуры объектива.
Цитологические методики
Суть цитологического метода - это оценка показателей морфологической структуры клеточных элементов с целью определения заболевания.
Методика диагностики лейкоцитоза по ГОСТ 25382-82
Лейкоцитоз можно определять с помощью микроскопа гематологическим, цитологическим и гистологическим методами.
Цитологический метод: мазки, приготовленные на предметных стеклах из свежей крови, пунктатов кроветворного костного мозга, селезенки, лимфоузлов и других органов и опухолей, а также препараты-отпечатки, приготовленные из материала, взятого при биопсии, или из кусочков органов при вскрытии животного, фиксируют в метиловом спирте, окрашивают по Паппенгейму и исследуют под микроскопом с иммерсионным объективом с увеличением 90х.

При гематологическом методе стоит задача подсчета лейкоцитов в счетной камере, либо дифференцированно (при условии, что их содержание с 1 см3 больше значения для здоровых животных). Тут стоит понимать, что можно есть выбор между системами – микроскоп с «ручным» управлением и моторизованная система с программным обеспечением для автоматического счета клеток. Такие системы есть как исследовательского, так и лабораторного класса.
Гистологический метод основан на исследовании ткани и уже на основании полученных результатов заключение о болезни.

Тут важен этап пробоподготовки, в частности микротомирования, для того, чтобы хорошо видеть разрастания или нарушения клеток в образце. Приготовленные срезы просматривают под микроскопом при естественном или искусственном освещении. При окуляре с увеличением 10х и объективе с увеличением 10х определяют общую структуру исследуемых органов с учетом изменения ткани в отдельных ее участках. И затем на окуляре с увеличением 20х и объективе с увеличением 40х выявляют детали изменений, обращая внимание на характер пролиферирующих клеток (тип, степень дифференцировки, зрелость) и интенсивность (выраженность) патогистологических изменений. Так же гистологическим методом определяют и лептоспироз. Типичные лептоспиры всегда окрашены в черный цвет, имеют S-образную форму с 1-2 изгибами или змеевидную форму с грубыми толстыми завитками, которые в отдельных случаях слабо заметны. Окружающая ткань окрашивается в буровато-желтый цвет.
Отличным будет выбор сета Nikon Eclipse E200, который уже озвучивался ранее, но с дополнительными окулярами с увеличением 15х.
Если смотреть на моторизованную модель – то это будет Nikon Eclipse Ni-E с полной моторизацией. Однако для диагностики одного лейкоцитоза такой микроскоп будет избыточен. Для современных микроскопов существует тенденция – гибкость. Это значит, что купив один микроскоп среднего/высокого класса его возможности можно менять, докупая необходимые комплектующие для реализации разных методик или использовать в одной комплектации для нескольких целей.
Методики с флуоресценцией
Методика флуоресцирующих антител по ГОСТ 26075-2013 (методика определения бешенства по ГОСТ 26075-2013)
В данном случае нас интересует сигнал от красителя FITC. Наблюдение возможно благодаря специфической реакции «антиген-антитело» и ярком свечении меток под действием спектра возбуждение ~470-495нм. Исследователь наблюдает желтовато-зелёное свечение антигена бешенства (в нейронах и вне клеток, в виде мелких ярких зелёных гранул, на фото), в окрашенных препаратах не пораженная вирусом бешенства мозговая ткань светится тусклым, серовато-желтым цветом. В качестве материала для исследований выступают как отпечатки мозга, так и мазки гомогенизированных мозгов.

Превосходных результатов можно добиться, используя следующие комплектации: Nikon Eclipse E200, новее Nikon Eclipse Ci при использовании оптики класса Plan Fluor или ещё лучше Plan Apochromat.
| MBA95000 Ci-L Main Body MBC91115 C-CSR1S Right Handle Ceramic Stage with 2S Holder MBB93115 C-TT Trinocular Tube T (FOV 22/25mm MBB73550 Y-TV55 TV Adapter 0.55x MQD42056 C-0.55X DS Relay Lens MAK10110 Eyepiece CFI 10X with diopter adjustment (FOV. 22mm) MAK99000 CFI Eyepiece Guard (for CFI 10X, CFI UW 10X) MBE94310 CI-FL Epi-fluorescence Attachment MBL71405 C-C Achromat/Aplanat Condenser N.A. 1.40 MXCL0023 CoolLED pE-300 White MB for Bayonnet MRH00101 CFI Plan Fluor 10X N.A. 0.30, W.D. 16.0 mm MRH00201 CFI Plan Fluor 20X N.A. 0.50, W.D. 2.1 mm MRL03401 CFI Plan Achromat 40X NCG, N.A. 0.65, W.D. 0.48mm, spring-loaded MRD04901 CFI Plan Apochromat NCG 100X Oil, N.A. 1.40, W.D. 0.16mm MXR00104 FITC-A-Basic Filter Cube (EX 475/35, DM 499, BA 530/43) | MCA76210 ECLIPSE E200 LED MV RS Main Body MXA22168 Immersion Oil F, 30cc MCB73101 E2-TF Trinocular Eyepiece Tube EU (100/0, 0/100) MCK70101 CFI E 10X Eyepiece EU (FN 20) MCL71100 E2 Abbe Condenser with objective position guide marking, N.A. 1.25 MRP70041 CFI E Plan Achromat 4X EU, N.A. 0.10, W.D. 30mm (FN 20) MRP70101 CFI E Plan Achromat 10X, N.A. 0.25, W.D. 7mm (FN 20) MRP70401 CFI E Plan Achromat 40X, N.A. 0.65, W.D. 0.65mm, spring loaded (FN 20) MRP71901 CFI E Plan Achromat 100X oil EU, N.A. 1.25, spring-loaded (FN 20) MCE74000 E2-FM Epi-Fluorescence Attachment MCE85750 C-LEDLH E200 Epi-FL Lamphouse MBF84736 C-LEDFL470 LED Unit E2 MBE34510 C-LEDLH470 Epi-FL Filter Cube (EX 470/40, DM 500, BA 534/55) MBF41300 Power Cord BE MQF52056 3-AC AC Adapter |
 |  |
Коммерческое предложение и консультация:
ЗАО "Аванта и К"
ЗАО "Аванта и К" - официальный дистрибьютор микроскопов Nikon в Беларуси
производитель
Nikon

 Аванта и К
Аванта и К













